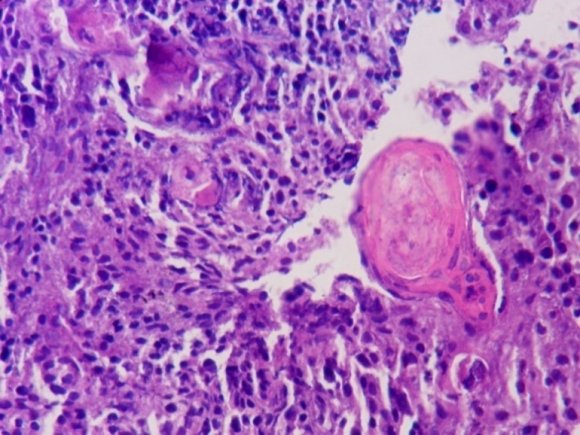
Figure 2 : Photomicrograph of Squamous cell carcinoma showing tumour diathesis, malignant cells with nucleomegaly, hyperchromatism and irregular nuclear margins (PAP X 400)

Introduction apanicolaou (Pap) smear is a simple, safe, noninvasive and effective method for detection of precancerous, cancerous and non-cancerous changes in the cervix. [1] Conventional cervical cytology is the most widely used cervical cancer screening test in the world and cytology screening programmes in several developed countries have been associated with impressive reduction in cervical cancer burden. [2] Squamous intraepithelial lesions are viewed as precancerous lesions exhibiting many of the morpho-Author ?: Department of Pathology, Government Medical College Patiala, (Punjab) India. e-mail: [email protected] logical characteristics of invasive carcinomas. Identification of these entities is the focus of cervical screening programs that aim to discover them and commence their treatment in order to prevent invasive disease. [3] Though data from the 20 populations based cancer registries in India indicate a steady decline in cervical cancer incidence rates over the last two decades, it still occupies second position and the risk of disease is still high. [3] Cervical carcinoma documents the remarkable effects of screening, early diagnosis, and curative therapy on the mortality rate. Death rate has declined for which the credit goes to Pap test and accessibility of cervix to colposcopy and biopsy. Though, the Pap smear is an effective screening test, yet confirmation of the diagnosis of cervical cancer or pre invasive lesions of cancer requires a biopsy of the cervix.
The aims of this study were to study the changes in cervical cytology with relation to age, parity and other presenting features, to classify cervical lesions into malignant and benign groups on cytological and histopathological basis and to correlate the changes observed in cervical cytology with cervical biopsy.
This study was done on 200 cases of Pap smears and cervical biopsies (including hysterectomy specimens). Most of the patients with symptoms suggestive of cervical disease were selected. However, some having gynaecological symptoms other than cervical disease were also included. Few cases reporting for routine screening were also included. A detailed clinical history especially age, duration of symptoms, parity, menstrual pattern and vaginal discharge were noted. The patients in whom both Pap smear and biopsy was available, were included in the study. The fixed cervical smears were subjected to staining according to Papanicolaou's method. The cytological interpretation of the smears was made according to the New 2001 Bethesda system. After grossing and processing, cervical biopsies were subjected to histopathological examination.
Age wise maximum number of patients were in fourth decade (54.50%), followed by fifth decade (Table-1). Duration of symptoms varied from few months to many years. Some patients presented within 1 year (79%), but few mainly cases with discharge and history of prolapse presented late (Table -2). In 200 cases, various symptoms were seen, some patients showed multiple symptoms. Majority of patients (58%) presented with vaginal discharge followed by irregular bleeding (47%). Menstrual changes were also seen in large number of patients. There was seen low usage of oral contraceptive pills in our study group (10.50%). Duration of OCP usage varied from few months to years, but long term usage was not seen in any case. On cytology, 59% were inflammatory smears and frank malignancy was reported in 10% cases, LSIL and HSIL was reported in 9% and 8.50% respectively (Table -
Cancer cervix is considered to be an ideal gynaecological malignancy for screening as it meets both test and disease criteria for screening. It has a long latent phase during which it can be detected as identifiable and treatable premalignant lesions which precede the invasive disease and the benefit of conducting screening for carcinoma cervix exceeds the cost involved. [4] Despite the success of cervical cancer screening programs, questions remain about the appropriate time to begin and end screening. This review explores epidemiologic and contextual data on cervical cancer screening to inform decisions about when screening should begin and end. The incidence and mortality rates from, cervical cancer that have had a Pap smear within 3 years have decreased since 2000.
In this study, more than half (54.50%) were aged between 31 to 45 years followed by 20.50% between 46 to 60 years. The mean age of patients with cancer in the present study was 51.94 years. This is close to that found by Biswas et al [5] and Missaoui et al. [6] Although, invasive cancer cervix is reported at all ages; it has two peaks, one at about 35 years and another above 50 years. The highest age of cervical cancer in the present study was 73 years and the lowest was 26 years. The mean age for non-cancer cases was 39.53 years. In this study, the most common symptoms was discharge per vaginum (58%) followed by irregular bleeding in 47% of the patients. Patients with cancer also presented with post-coital bleeding and in cases of older age group post menopausal bleeding was seen. Symptomatic presentation was similar to some extent as seen by Ikram et al [7] .
In this study, 59% patients had the cytological diagnosis of benign/ inflammatory and carcinoma was present in 10% of the cases. This is comparable to Saha and Thapa [8] in which benign cases were 51.16% and carcinoma was diagnosed in 6.97% of the cases. Most common cancer in the present study was squamous cell carcinoma (85.18%). This study showed results similar to those seen by Ikram et al [7] (83.33%).
As regards the various histopathological varieties of SCC, the present study found an incidence of 67.39% for moderately differentiated SCC, 23.91% for well differentiated, 8.70% for poorly differentiated. Thus, the findings of the present study are consistent with that
It is concluded that most commonly seen problem, infection, can be controlled with good hygiene. Cervical carcinoma is seen in large number of patients. Pap is a relatively less invasive and a simple procedure to diagnose cervical lesions in developing countries. But sometimes, there can be obscuring of the cellular details by blood, especially in malignant cases. In such cases, biopsy is helpful and confirmatory. of Missaoui et al [6] in that moderately differentiated large

| 2014 | ||||
| Year | ||||
| Volume XIV Issue IV Version I | Age group (Years) 18-30 31-45 46-60 > 60 | Distribution (n=200) No. %age 29 14.50 109 54.50 41 20.50 21 10.50 | ||
| ( ) | Total | 200 | 100 | |
| Table 2 : showing duration of symptoms | ||||
| Duration (Years) | Distribution (n=200) No. | %age | ||
| Up to 1 | 158 | 79.00 | ||
| 1-3 | 25 | 12.50 | ||
| 4-6 | 11 | 05.50 | ||
| >6 | 06 | 03.00 | ||
| Total | 200 | 100 | ||
| Table 3 : showing cytological diagnosis | ||||
| Diagnosis | Distribution (n=200) No. %age | |||
| Unsatisfactory smear | 08 | 4.00 | ||
| Inflammatory | 118 | 59.00 | ||
| ASCUS/H | 19 | 9.50 | ||
| LSIL | 18 | 9.00 | ||
| HSIL | 17 | 8.50 | ||
| Frank malignancy | 20 | 10.00 | ||
| Total | 200 | 100 | ||
| Histopathological Diagnosis | No. | Cytological Diagnosis Unsatisfactory Inflammatory ASCUS/H LSIL | HSIL | Ca | ||||
| Infections | 115 | - | 108 | 07 | - | - | - | |
| Carcinoma | 54 | 08 | - | - | 12 | 14 | 20 | |
| Dysplasia | 25 | - | 04 | 12 | 06 | 03 | - | |
| Benign tumors | 06 | - | 06 | - | - | - | - | |
| Total | 200 | 08 | 118 | 19 | 18 | 17 | 20 | |
| Table 6 : showing means age | ||||||||
| Variable | Cervical Ca (n=54) Mean SD | No Ca (n=146) Mean | SD | |||||
| Mean | 51.94 | 12.30 | 39.53 | 09.66 | ||||
| T | 7.469 | |||||||
| Df | 198 | |||||||
| P | < 0.001 | |||||||
| Significance | Highly Significant | |||||||
| V. | ||||||||
We thank the patients and technical staff of Pathology Department GMC Patiala for processing the Pap smears and cervical biopsies.
Sexual Risk Factors for Cervical Cancer among Rural Indian Women: A Case-Control Study. Int J Epidemiol 1997. 26 (3) p. 491.
Pap Smear Screening for Pre-cancerous Conditions of the Cervical Cancer. Pak J Med Res 2005. 44 (3) p. .
Carcinoma of cervix. Professional Dec Med J 2005. 12 (4) p. .
Cervix cancer in Tunisia: clinical and pathological study. Asian pacific. J cancer prevention 2010. 11 p. .
Screening for cervical cancer: An overview. J Obstet Gynecol India 2006. 56 p. .
Correlation of cervical cytology with cervical histology. Kathmandu University Medical Journal 2005. 3 (3) p. .
Effective screening programmes for cervical cancer in low and middle income developing countries. Bulletin of WHO 2001. 79 p. .